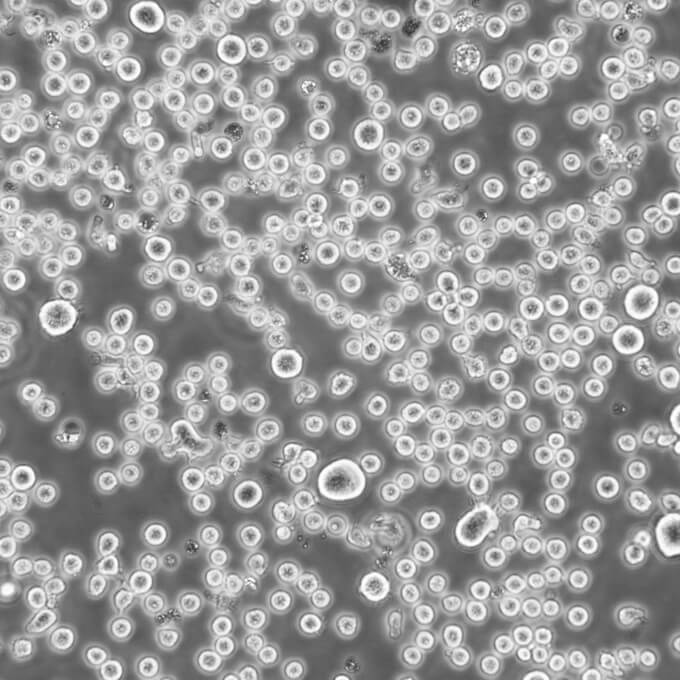
H1703 Cells#人肺腺鳞癌细胞系源头种子库|培养基|STR图谱

"H1703 Cells#人肺腺鳞癌细胞系源头种子库|培养基|STR图谱
换液周期:每周2-3次
生长特性:贴壁生长
背景信息:该细胞1987年建系,源自一位54岁患有非小细胞肺癌的白人男性,该患者为吸烟者。
准确判断胰酶消化是否完成,首先,观察细胞形态变化是判断胰酶消化程度的重要依据。在加入胰酶后,随着消化的进行,原本贴壁生长的细胞会逐渐变圆。当大部分细胞呈现出圆形,且细胞之间的连接变得松散时,说明消化正在进行中。如果细胞完全脱离培养瓶底部,变成单个的圆形细胞悬浮在消化液中,这通常是消化完成的一个重要标志。此时,在显微镜下观察,细胞应该是圆润、饱满且边界清晰的。其次,可以通过轻轻拍打培养瓶或轻轻晃动培养板来辅助判断。如果细胞很容易从瓶底或板底脱落并在液体中悬浮,说明消化程度可能已经比较合适。但要注意动作要轻柔,避免过度剧烈的晃动对细胞造成损伤。另外,消化时间也是一个参考因素。一般来说,在开始消化时,可以先根据经验设定一个大致的消化时间,然后在这个时间点前后密切观察细胞的状态。如果消化时间过长,可能会导致细胞受损,影响细胞的活性和功能;而消化时间过短,则可能导致细胞没有完全分离,影响传代效果。还可以通过观察消化液的浑浊程度来判断。在消化开始时,消化液通常是比较澄清的。随着消化的进行,当细胞逐渐脱落进入消化液中,消化液会变得浑浊。当浑浊度达到一定程度,且细胞形态也符合消化完成的特征时,可以认为消化好了。总之,在细胞传代用胰酶消化时,需要综合考虑细胞形态变化、拍打或晃动的反应、消化时间以及消化液的浑浊程度等多个因素,来准确判断消化是否完成。
H-446 Cells;背景说明:该细胞是1982年由CarneyD和GazdarAF等从一位小细胞肺癌患者的胸腔积液中建立的。细胞的原始形态并不具有小细胞肺癌特征。这个细胞株是小细胞肺癌的生化和形态学上的变种,表达神经元特有的烯醇酶和脑型肌酸激酶同工酶;左旋多巴脱羧酶、蚕素、抗利尿激素、催产素或胃泌激素释放肽未达到可检测水平。与正常细胞相比,该细胞c-mycDNA序列扩增约20倍,RNA增加15倍。最初传代培养基用含有5%FBS的RPMI1640,另外添加10nM化可的松、0.005mg/ml胰岛素、0.01mg/ml转铁;传代方法:1:2传代;生长特性:贴壁/悬浮生长,混合;形态特性:上皮样;相关产品有:U251-MG细胞、Hs 888.T细胞、A9(Hamprecht)细胞
SNU484 Cells;背景说明:详见相关文献介绍;传代方法:1:2传代;生长特性:贴壁或悬浮,详见产品说明书部分;形态特性:详见产品说明书;相关产品有:Hs819T细胞、NCIH64细胞、OV-2008细胞
G-Olig2 Cells;背景说明:胚胎干细胞;129X1/SvJ;传代方法:1:2-1:3传代;每周换液2-3次。;生长特性:贴壁;形态特性:详见产品说明书;相关产品有:C3H10T1-2细胞、SNUC1细胞、Calu 6细胞
MNNG Cells;背景说明:骨肉瘤;女性;传代方法:1:2-1:3传代;每周换液2-3次。;生长特性:贴壁;形态特性:详见产品说明书;相关产品有:I90细胞、Clone 929细胞、SW 839细胞
┈订┈购(技术服务)┈热┈线:1┈3┈6┈4┈1┈9┈3┈0┈7┈9┈1【微信同号】┈Q┈Q:3┈1┈8┈0┈8┈0┈7┈3┈2┈4;
产品包装:复苏发货:T25培养瓶(一瓶)或冻存发货:1ml冻存管(两支)
传代比例:1:2-1:4(首次传代建议1:2)
细胞常规培养传代流程(请严格遵照无菌操作):1)吸出原培养瓶中的培养基,PBS缓冲润洗细胞两次,加2-3ml 0.25%胰酶进行消化细胞(注意把握消化时间,通常控制在1-2min);2)镜下观察消化情况,在细胞边缘缩小,贴壁松动时(不建议消化到细胞漂浮)去掉胰酶,加6-8ml完全培养基,轻轻吹打细胞层,尽量把细胞层吹落,吹散;3)取部分细胞悬转移到新的培养皿/瓶中,添加适当的完全培养基,把细胞悬打匀,于培养箱中培养;4)注意培养基PH值变化情况,定期换(每周2-3次),待细胞密度达到80%以后重复1项操作或者冻存;别注意:(如使用公共实验室或者初次接触细胞培养,建议添加双抗培养)1)收到细胞后请尽快更换为含15%血清的新鲜培养基,如因殊情况需要继续使用原瓶,请在原瓶培养基中额外添加10%的血清,(原瓶培养基的继续使用时间Zui长不宜超过72小时);2)贴壁细胞收到当天切忌立刻消化,请将细胞换后放置培养箱孵育到第二天再做消化传代,请YOU先选择直径6cm的培养皿进行传代培养;3)如签收时出现培养瓶壁破裂,漏等情况请及时做HAO照片记录并联系实验室。
来源说明:细胞主要来源ATCC、ECACC、DSMZ、RIKEN等细胞库
no.11 Cells;背景说明:详见相关文献介绍;传代方法:1:2传代;生长特性:贴壁生长;形态特性:上皮样;相关产品有:HCE-2 [50.B1]细胞、THC-8307细胞、HCA-7细胞
no.11 Cells;背景说明:详见相关文献介绍;传代方法:1:2传代;生长特性:贴壁生长;形态特性:上皮样;相关产品有:HCE-2 [50.B1]细胞、THC-8307细胞、HCA-7细胞
MM.1S Cells;背景说明:详见相关文献介绍;传代方法:1:2-1:4传代,2-3天换液1次。;生长特性:混合生长;形态特性:淋巴母细胞样;相关产品有:HCC-1419细胞、C-4I细胞、F36P细胞
NCI-H2126 Cells;背景说明:详见相关文献介绍;传代方法:1:2-1:4传代,每周2-3次。;生长特性:贴壁生长;形态特性:上皮细胞样;相关产品有:NCIH1651细胞、BNL-HCC细胞、H-441细胞
CAMA Cells;背景说明:详见相关文献介绍;传代方法:1:3—1:4传代;每周换液2-3次。;生长特性:贴壁生长;形态特性:上皮细胞贴壁斑块;紧凑,很少汇合;相关产品有:CAL 51细胞、TSU-Pr1细胞、H929细胞
物种来源:人源、鼠源等其它物种来源
H1703 Cells#人肺腺鳞癌细胞系源头种子库|培养基|STR图谱
形态特性:上皮细胞样
┈订┈购(技术服务)┈热┈线:1┈3┈6┈4┈1┈9┈3┈0┈7┈9┈1【微信同号】┈Q┈Q:3┈1┈8┈0┈8┈0┈7┈3┈2┈4;
DSMZ菌株保藏中心成立于1969年,是德国的国家菌种保藏中心。该中心一直致力于细菌、真菌、质粒、抗菌素、人体和动物细胞、植物病毒等的分类、鉴定和保藏工作。DSMZ菌种保藏中心是欧洲规模最大的生物资源中心,保藏有动物细胞500多株。Riken BRC成立于1920年,是英国的国家菌种保藏中心。该中心一直致力于细菌、真菌、植物病毒等的分类、鉴定和保藏工作。日本Riken BRC(Riken生物资源保藏中心)是全球三大典型培养物收集中心之一。Riken保藏中心提供了很多细胞系。在世界范围内,这些细胞系,都在医学、科学和兽医中具有重要意义。Riken生物资源中心支持了各种学术、健康、食品和兽医机构的研究工作,并在世界各地不同组织的微生物实验室和研究机构中使用。
Abcam HCT 116 STC2 KO Cells(提供STR鉴定图谱)
AG08472 Cells(提供STR鉴定图谱)
BayGenomics ES cell line HMA257 Cells(提供STR鉴定图谱)
BayGenomics ES cell line XB476 Cells(提供STR鉴定图谱)
BON1-MEN1-KO Cells(提供STR鉴定图谱)
CNE 19 Cells(提供STR鉴定图谱)
DA03714 Cells(提供STR鉴定图谱)
F-3-3 Cells(提供STR鉴定图谱)
GM07415 Cells(提供STR鉴定图谱)
NCIH250 Cells;背景说明:小细胞肺癌;男性;传代方法:1:2-1:3传代;每周换液2-3次。;生长特性:半贴壁;形态特性:详见产品说明书;相关产品有:NCIH322细胞、8305-C细胞、SNU-761细胞
FRTL 5 Cells;背景说明:甲状腺;自发永生;Fischer;传代方法:1:2-1:3传代;每周换液2-3次。;生长特性:贴壁;形态特性:详见产品说明书;相关产品有:RAW264细胞、OCI/AML-5细胞、NS1-Ag 4/1细胞
NCIH1703 Cells;背景说明:该细胞1987年建系,源自一位54岁患有非小细胞肺癌的白人男性,该患者为吸烟者。;传代方法:1:3—1:6传代,每周换液2—3次;生长特性:贴壁生长;形态特性:上皮细胞样;相关产品有:NK-10A细胞、Hs 683细胞、A-172MG细胞
CWR22Rv1 Cells;背景说明:22RV1是来自异种移植(在阉割引起前列腺癌衰退又在其父亲的雄性激素信赖型CWR22嫁接后复发的小鼠中连续传代)的人前列腺癌上皮细胞系。此细胞系表达前列腺特异抗原。二羟基睾丸脂酮轻微刺激细胞生长,经westernblot检测溶解产物与抗雄性激素受体抗体起免疫反应。EGF刺激细胞生长,但TGFβ-1不能抑制细胞生长。该细胞在裸鼠中成瘤。;传代方法:消化3-5分钟。1:2。3天内可长满。;生长特性:贴壁生长;形态特性:上皮细胞;相关产品有:NCI-H2110细胞、Det 562细胞、HME-1细胞
P3/ag Cells;背景说明:骨髓瘤;传代方法:1:2-1:3传代;每周换液2-3次。;生长特性:悬浮;形态特性:详见产品说明书;相关产品有:HECCL-1细胞、NCI-HUT-292细胞、B-cell with DC Morphology细胞
Ketr-3 Cells;背景说明:详见相关文献介绍;传代方法:1:2传代;生长特性:贴壁生长 ;形态特性:详见产品说明书;相关产品有:C42细胞、CCD 966SK细胞、MES-SA/Dx5细胞
Pt K1 Cells;背景说明:详见相关文献介绍;传代方法:1:2-1:3传代;每周换液2-3次。;生长特性:贴壁或悬浮,详见产品说明书部分;形态特性:详见产品说明书;相关产品有:Ly18细胞、PZ-HPV-7细胞、H2452细胞
H1703 Cells#人肺腺鳞癌细胞系源头种子库|培养基|STR图谱
MiaPaca.2 Cells;背景说明:详见相关文献介绍;传代方法:1:2传代;;生长特性:贴壁生长;形态特性:详见产品说明书;相关产品有:MGHU1细胞、L-428细胞、MDA-MB-330细胞
Emory University-3 Cells;背景说明:B淋巴细胞白血病;男性;传代方法:1:2-1:3传代;每周换液2-3次。;生长特性:悬浮;形态特性:详见产品说明书;相关产品有:NCI747细胞、CHP100细胞、Capan-2细胞
MonoMac1 Cells;背景说明:急性单核细胞白血病;男性;传代方法:1:2-1:3传代;每周换液2-3次。;生长特性:悬浮;形态特性:详见产品说明书;相关产品有:HSC-3细胞、95C细胞、C38细胞
SK-ES-1 Cells;背景说明:详见相关文献介绍;传代方法:1:2-1:5传代;每周换液2-3次;生长特性:贴壁或悬浮,详见产品说明书部分;形态特性:上皮样;相关产品有:CD18/HPAF细胞、GCT细胞、N87细胞
MCF/Adr Cells;背景说明:详见相关文献介绍;传代方法:1:2-1:3传代;每周换液2-3次。;生长特性:贴壁或悬浮,详见产品说明书部分;形态特性:详见产品说明书;相关产品有:BE(2)M-17细胞、BEL-7404细胞、CCC-ESF-1细胞
CBRH7919 Cells;背景说明:详见相关文献介绍;传代方法:1:2-1:3传代;每周换液2-3次。;生长特性:贴壁或悬浮,详见产品说明书部分;形态特性:详见产品说明书;相关产品有:CHP100细胞、MDA-PCa-2b细胞、BT 325细胞
IALM Cells;背景说明:详见相关文献介绍;传代方法:1:2-1:3传代;每周换液2-3次。;生长特性:贴壁或悬浮,详见产品说明书部分;形态特性:详见产品说明书;相关产品有:DMS273细胞、COS7细胞、C28/I2细胞
SUM 149 Cells;背景说明:乳腺癌;女性;传代方法:1:2-1:3传代;每周换液2-3次。;生长特性:贴壁;形态特性:详见产品说明书;相关产品有:Detroit-562细胞、CHL1细胞、HT(H9)细胞
┈订┈购(技术服务)┈热┈线:1┈3┈6┈4┈1┈9┈3┈0┈7┈9┈1【微信同号】┈Q┈Q:3┈1┈8┈0┈8┈0┈7┈3┈2┈4;
GBC-SD Cells;背景说明:GBC-SD 细胞株是王展明等2000年从一位61岁的男性低分化胆囊癌患者中建立的。 细胞的形状有多边形、纺锤形和正方形。 分泌CEA和CA19-9。倍增时间大约为21.4小时。 可移植到裸鼠。 生成的肿瘤与原发肿瘤相似。;传代方法:1:2传代;生长特性:贴壁生长;形态特性:上皮细胞样;相关产品有:Alexander细胞、Hx-147细胞、PL5细胞
T. T Cells;背景说明:详见相关文献介绍;传代方法:10^5 cells/60mm dish;生长特性:贴壁生长;形态特性:上皮细胞样;相关产品有:Experimental Mammary Tumour-6细胞、FDC-P1细胞、HSC-5 [Human skin squamous cell carcinoma]细胞
KRCY Cells;背景说明:肾透明细胞癌;女性;传代方法:1:2-1:3传代;每周换液2-3次。;生长特性:贴壁;形态特性:详见产品说明书;相关产品有:MDCK-II细胞、Ly18细胞、MDA231-LM2细胞
MEL-526 Cells;背景说明:黑色素瘤;传代方法:1:2-1:3传代;每周换液2-3次。;生长特性:贴壁;形态特性:详见产品说明书;相关产品有:Tj-905细胞、HEK 293-H细胞、WILL2细胞
MDAMB435 Cells;背景说明:乳腺癌;传代方法:1:2-1:3传代;每周换液2-3次。;生长特性:贴壁;形态特性:详见产品说明书;相关产品有:NCIH647细胞、PTK1细胞、UACC 812细胞
HS 683T Cells;背景说明:该细胞源自76岁白人男性的左颞叶侧胶质瘤组织,有微绒毛,无桥粒。 ;传代方法:1:4传代,每周换液2次;生长特性:贴壁生长;形态特性:成纤维细胞;相关产品有:NCI-H522细胞、U266细胞、3T3-Swiss细胞
HDLM-2 Cells;背景说明:霍奇金淋巴瘤;男性;传代方法:1:2-1:3传代;每周换液2-3次。;生长特性:悬浮;形态特性:详见产品说明书;相关产品有:MHCC-97细胞、D407细胞、H2106细胞
MCA 205 Cells;背景说明:纤维肉瘤;传代方法:1:2-1:3传代;每周换液2-3次。;生长特性:贴壁;形态特性:详见产品说明书;相关产品有:SW 1417细胞、Vero-E6细胞、SCL1细胞
CCC-HSF-1 Cells;背景说明:皮肤;成纤维 Cells;传代方法:1:2-1:3传代;每周换液2-3次。;生长特性:贴壁;形态特性:详见产品说明书;相关产品有:McArdle RH-7777细胞、UMNSAH-DF-1细胞、2780细胞
Sp2/O-Ag14 Cells;背景说明:该细胞是由绵羊红细胞免疫的BALB/c小鼠脾细胞和P3X63Ag8骨髓瘤细胞融合得到的。该细胞不分泌免疫球蛋白,对20μg/ml的8-氮鸟嘌呤有抗性,对HAT比较敏感;该细胞可以作为细胞融合时的B细胞组分用于制备杂交瘤;鼠痘病毒阴性。;传代方法:1:2传代;生长特性:悬浮生长;形态特性:淋巴母细胞样;圆形;相关产品有:MUVEC细胞、SJ-RH30细胞、H-87细胞
Ramos (RA 1) Cells;背景说明:详见相关文献介绍;传代方法:1:2-1:3传代;每周换液2-3次。;生长特性:贴壁或悬浮,详见产品说明书部分;形态特性:详见产品说明书;相关产品有:hESC细胞、K7M2 wt细胞、SW-1990细胞
RBVEC Cells;背景说明:脑静脉;内皮 Cells;传代方法:1:2-1:3传代;每周换液2-3次。;生长特性:贴壁;形态特性:详见产品说明书;相关产品有:OCI AML2细胞、HDLM2细胞、HBZY 1细胞
BIU-87/Adr Cells;背景说明:详见相关文献介绍;传代方法:1:2-1:3传代;每周换液2-3次。;生长特性:贴壁或悬浮,详见产品说明书部分;形态特性:详见产品说明书;相关产品有:OVCA 432细胞、PF-382细胞、KYSE50细胞
H69/VDS Cells(提供STR鉴定图谱)
HAP1 RAPGEF5 (-) Cells(提供STR鉴定图谱)
HG01683 Cells(提供STR鉴定图谱)
HuL-1 Cells(提供STR鉴定图谱)
L6E9 Cells(提供STR鉴定图谱)
MtT/E-2 Cells(提供STR鉴定图谱)
OP-9S/LMJSN Cells(提供STR鉴定图谱)
Royan N3 Cells(提供STR鉴定图谱)
T3-HA Cells(提供STR鉴定图谱)
Ubigene Hep G2 PCCA KO Cells(提供STR鉴定图谱)
XYFMGC10S Cells(提供STR鉴定图谱)
AV2G1 Cells(提供STR鉴定图谱)
Hs840_T Cells;背景说明:详见相关文献介绍;传代方法:1:4—1:8传代,每周换液2—3次;生长特性:贴壁生长;形态特性:成纤维细胞;相关产品有:LIXC002细胞、578T细胞、EoL-1 cell细胞
KOSC-2 cl3-43 Cells;背景说明:详见相关文献介绍;传代方法:2.2 x 10^4 cells/ml ;生长特性:贴壁生长;形态特性:上皮样;相关产品有:Calu6细胞、MDCC-MSB1细胞、MD Anderson-Metastatic Breast-175-VIII细胞
130-T Cells;背景说明:详见相关文献介绍;传代方法:1:2-1:4传代,3-4天换液1次。;生长特性:贴壁生长;形态特性:梭型和大的多核细胞;相关产品有:G361-mel细胞、Pt-K2细胞、SUM 159PT细胞
CCF-STTG1 Cells;背景说明:详见相关文献介绍;传代方法:1:3—1:6传代;每周换液2-3次;生长特性:贴壁生长;形态特性:星形胶质细胞;相关产品有:MT-2J细胞、ME 180细胞、NCI-H1184细胞
P-3J Cells;背景说明:详见相关文献介绍;传代方法:每周2-3次。;生长特性:悬浮生长;形态特性:淋巴母细胞;相关产品有:TE14细胞、NCI-H1944细胞、VMCUB-1细胞
OVCAR4 Cells;背景说明:详见相关文献介绍;传代方法:1:2-1:3传代;每周换液2-3次。;生长特性:贴壁或悬浮,详见产品说明书部分;形态特性:详见产品说明书;相关产品有:PL45细胞、Duke University 145细胞、H-2195细胞
NCI-H1299 Cells;背景说明:这株细胞来源于一个淋巴结转移。患者接受了初期放疗。细胞均一性的部分缺失p53蛋白,并缺少p53蛋白表达。细胞可以合成0.1pmol/毫克蛋白的NMB蛋白,而不合成促胃液释放肽(GRP)。;传代方法:1:2传代;3天传代一次。;生长特性:贴壁生长;形态特性:上皮样;多角形;相关产品有:COR-L23细胞、Madison 109细胞、C643细胞
MESSA Cells;背景说明:详见相关文献介绍;传代方法:1:6-1:8传代;每周2-3次。;生长特性:贴壁生长;形态特性:成纤维细胞样 ;相关产品有:M109细胞、KYSE-70细胞、L1210细胞
PC-3M-2B4 Cells;背景说明:前列腺癌;骨转移;男性;传代方法:1:2-1:3传代;每周换液2-3次。;生长特性:贴壁;形态特性:详见产品说明书;相关产品有:GBC-SD细胞、HUT125细胞、Jurkat77细胞
Hs274T Cells;背景说明:详见相关文献介绍;传代方法:1:2传代,每周换液2-3次。;生长特性:贴壁生长;形态特性:成纤维细胞;相关产品有:NCI-H1437细胞、CAOV3细胞、PC-9/S1细胞
H-2195 Cells;背景说明:详见相关文献介绍;传代方法:1:2-1:3传代;每周换液2-3次。;生长特性:贴壁或悬浮,详见产品说明书部分;形态特性:详见产品说明书;相关产品有:H-226细胞、Hs683细胞、D324 Med细胞
Hs 742.T Cells;背景说明:详见相关文献介绍;传代方法:1:2—1:4传代,每周换液2—3次;生长特性:贴壁生长;形态特性:成纤维细胞;相关产品有:High5细胞、H-1435细胞、B16 subline B78细胞
Y 1 Cells;背景说明:详见相关文献介绍;传代方法:1:2-1:3传代;每周换液2-3次。;生长特性:贴壁或悬浮,详见产品说明书部分;形态特性:详见产品说明书;相关产品有:MESSA/Dx5细胞、U-251-MG细胞、P3J HR-1细胞
Mink Lung Cells;背景说明:详见相关文献介绍;传代方法:1:2-1:3传代;每周换液2-3次。;生长特性:贴壁或悬浮,详见产品说明书部分;形态特性:详见产品说明书;相关产品有:NCI-H1915细胞、HCC-44细胞、LNCaP clone FGC细胞
Jurkat Cells;背景说明:该细胞源自一位14岁患有T淋巴细胞白血病男性的外周血;传代方法:保持细胞密度在3—9×105cells/ml之间,1:5—1:10传代,每周换液2—3次;生长特性:悬浮生长;形态特性:圆形,单个或呈片;相关产品有:Pt-K1细胞、ACC2细胞、mRMEC细胞
SNU601 Cells;背景说明:详见相关文献介绍;传代方法:1:2-1:3传代;每周换液2-3次。;生长特性:贴壁或悬浮,详见产品说明书部分;形态特性:详见产品说明书;相关产品有:KYSE0030细胞、WiDr-TC细胞、KPNRTBM1细胞
R 2 C Cells;背景说明:睾丸间质瘤;雄性;Wistar Furth;传代方法:1:2-1:3传代;每周换液2-3次。;生长特性:贴壁;形态特性:详见产品说明书;相关产品有:CCD-841-CoTr细胞、MDA-468细胞、HCEC-12细胞
Mel-624 Cells;背景说明:黑色素瘤;男性;传代方法:1:2-1:3传代;每周换液2-3次。;生长特性:贴壁;形态特性:详见产品说明书;相关产品有:CCK81细胞、OCI-Ly8细胞、KYSE-30细胞
Hs-695-T Cells;背景说明:详见相关文献介绍;传代方法:1:2-1:4传代,2-3天换液1次。;生长特性:贴壁生长;形态特性:上皮细胞;相关产品有:H226细胞、JB6 Cl 30细胞、OVCA-420细胞
NCI-HUT-292 Cells;背景说明:详见相关文献介绍;传代方法:1:3-1:8传代;2-3天换液1次。;生长特性:贴壁生长;形态特性:上皮样;相关产品有:NCIH2291细胞、H322T细胞、SUDHL4细胞
A375mel Cells;背景说明:A375源自一位54岁女性,是Giard DJ等人建立的一系列细胞株中的一株。该细胞可在免疫抑制小鼠上成瘤,在琼脂上形成克隆。;传代方法:1:2-1:3传代;每周换液2-3次。;生长特性:贴壁;形态特性:上皮细胞样;相关产品有:SKLMS-1细胞、SGC-7901细胞、JHH2细胞
B10BR Cells;背景说明:永生化黑素 Cells;传代方法:1:2-1:3传代;每周换液2-3次。;生长特性:贴壁;形态特性:详见产品说明书;相关产品有:NCI-H838细胞、OVCA5细胞、IPEC-1细胞
BIC1 Cells;背景说明:食管腺癌;男性;传代方法:1:2-1:3传代;每周换液2-3次。;生长特性:贴壁;形态特性:详见产品说明书;相关产品有:NCI-H1048细胞、TR 146细胞、AHH-1细胞
MDCC MSB1 Cells;背景说明:淋巴瘤;传代方法:1:2-1:3传代;每周换液2-3次。;生长特性:悬浮;形态特性:详见产品说明书;相关产品有:MLA-144细胞、DoTc2-4510细胞、Porcine Kidney-13细胞
HS-766-T Cells;背景说明:详见相关文献介绍;传代方法:1:2—1:8传代,每周换液2—3次;生长特性:贴壁生长;形态特性:上皮细胞;相关产品有:HuCCT-1细胞、COLO 394细胞、ONS-76细胞
SW-13 Cells;背景说明:详见相关文献介绍;传代方法:1:2-1:3传代;每周换液2-3次。;生长特性:贴壁或悬浮,详见产品说明书部分;形态特性:详见产品说明书;相关产品有:B35细胞、RH35细胞、MCF-7B细胞
LoVo Cells;背景说明:LoVo建自1971年,从诊断为结肠腺癌的56岁男性白人的一个转移到左锁骨上区的肿瘤结节建系。癌基因C-myc,K-ras,H-ras,N-ras,Myb,sis和fos的表达呈阳性。癌基因N-myc的表达未做检测。它在裸鼠中能成瘤。与107细胞联合皮下接种5只裸鼠21天后全部成瘤。表达肿瘤特异的核基质蛋白蛋白CC-3和CC-4。;传代方法:1:3传代,2-3天换液一次;生长特性:贴壁生长;形态特性:上皮样;相关产品有:KYSE 270细胞、SNU878细胞、NCI-H1105细胞
Line 870 Emory University-4 Cells;背景说明:儿童急性髓系白血病;传代方法:1:2-1:3传代;每周换液2-3次。;生长特性:悬浮;形态特性:详见产品说明书;相关产品有:CCD841CoTr细胞、U343细胞、Wien-133细胞
IEC6 Cells;背景说明:详见相关文献介绍;传代方法:1:2传代;生长特性:贴壁生长;形态特性:上皮细胞样;相关产品有:HEK 293-EBNA细胞、COR-L23细胞、ME-180细胞
J 82 Cells;背景说明:电子显微镜下未观察到桥粒但观察到数目不同的粗面内质网和突出微丝。 含ras (H-ras)癌基因。;传代方法:1:2传代;生长特性:贴壁生长;形态特性:上皮细胞样;相关产品有:RK-13细胞、MNNG-HOS (TE 85, clone F-5)细胞、REC细胞
OVCA 420 Cells;背景说明:卵巢癌;女性;传代方法:1:2-1:3传代;每周换液2-3次。;生长特性:贴壁;形态特性:详见产品说明书;相关产品有:IOSE 80细胞、RT-112细胞、NK92MI细胞
┈订┈购(技术服务)┈热┈线:1┈3┈6┈4┈1┈9┈3┈0┈7┈9┈1【微信同号】┈Q┈Q:3┈1┈8┈0┈8┈0┈7┈3┈2┈4;
HPAEC Cells;背景说明:肺动脉;内皮 Cells;传代方法:1:2-1:3传代;每周换液2-3次。;生长特性:贴壁;形态特性:详见产品说明书;相关产品有:Vero细胞、FBHE细胞、SK-SH-SY5Y细胞
HR-8348 Cells;背景说明:详见相关文献介绍;传代方法:1:2-1:3传代;每周换液2-3次。;生长特性:贴壁或悬浮,详见产品说明书部分;形态特性:详见产品说明书;相关产品有:MV(4;11)细胞、NCI-H441细胞、PLC/PRF5细胞
H1703 Cells#人肺腺鳞癌细胞系源头种子库|培养基|STR图谱
Michigan Cancer Foundation-10A Cells;背景说明:乳腺;上皮细胞;自发永生;女性;传代方法:1:2-1:3传代;每周换液2-3次。;生长特性:贴壁;形态特性:详见产品说明书;相关产品有:ST486细胞、CL1-5细胞、HSC4细胞
ISHI Cells;背景说明:详见相关文献介绍;传代方法:1:3传代,3-4天换液一次;生长特性:贴壁生长;形态特性:上皮样;相关产品有:SF17细胞、HUASMC细胞、H322细胞
TE671 Cells;背景说明:胚胎性横纹肌肉瘤;女性;传代方法:1:2-1:3传代;每周换液2-3次。;生长特性:贴壁;形态特性:详见产品说明书;相关产品有:AU-Mel细胞、WI-38细胞、DHL6细胞
RGC-5 Cells;背景说明:详见相关文献介绍;传代方法:1:2传代;生长特性:贴壁生长;形态特性:详见产品说明书;相关产品有:HLEC细胞、NR8383细胞、PaTu-8988s细胞
KTCTL140 Cells;背景说明:肾透明细胞癌;女性;传代方法:1:2-1:3传代;每周换液2-3次。;生长特性:贴壁;形态特性:详见产品说明书;相关产品有:H596细胞、Karpas 299细胞、HCC 94细胞
BayGenomics ES cell line RRO227 Cells(提供STR鉴定图谱)
BayGenomics ES cell line YHB312 Cells(提供STR鉴定图谱)
H7-9 Cells(提供STR鉴定图谱)
PCRP-AGO3-1C5 Cells(提供STR鉴定图谱)
AS-D-653-TC Cells(提供STR鉴定图谱)
HPS0130 Cells(提供STR鉴定图谱)
"